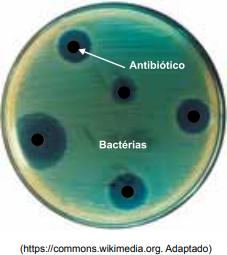

Resolução passo a passo com explicação detalhada
Biologia > Bacteriologia > Bactérias, Saúde e Antibióticos
Bactérias, Saúde e Antibióticos aparece em ~0% das questões de Biologia (72 questões no banco).
IFSC 2025
Questão 28
Leia o Texto XVI.TEXTO XVIEsperança contra a resistência bacterianaA resistência
UNICAMP 2024
Questão 19
Para cada classe de antibiótico à esquerda, identifique o mecanismo de ação da l
UTFPR 2024
Questão 41
“A Organização Mundial da Saúde (OMS) fez um alerta para altos níveis de resistê
UNICAMP 2024
Questão 46
Um grupo de pesquisadores estudou a atividade antibacteriana – em ação sobre dua